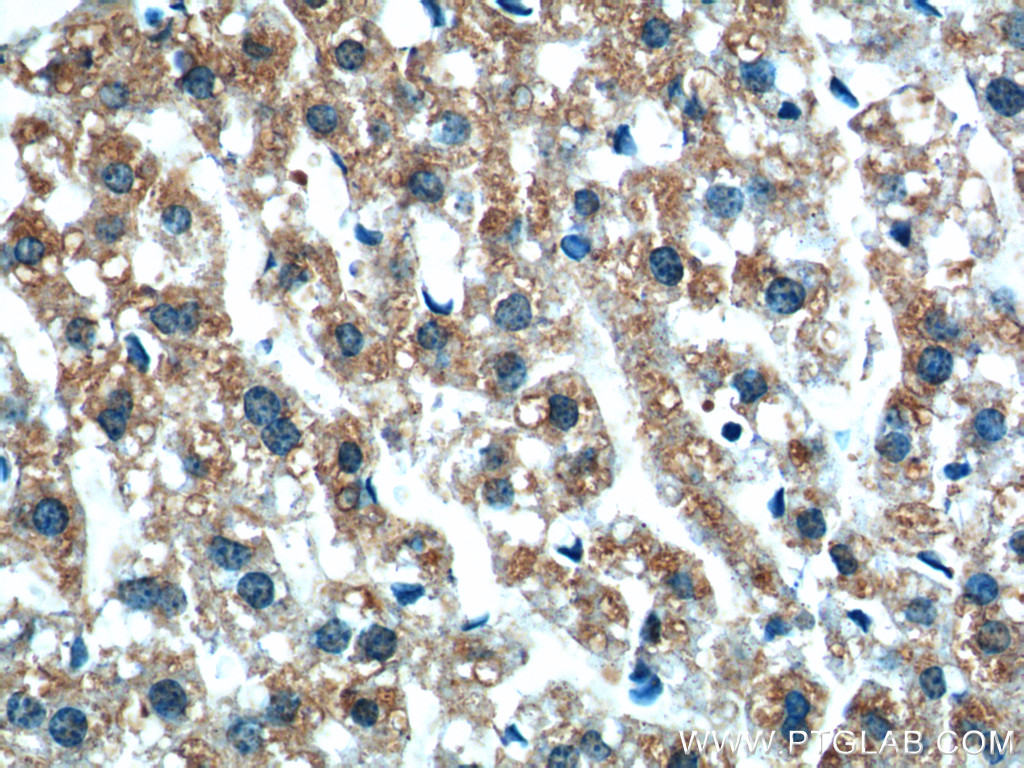

验证数据展示
经过测试的应用
| Positive WB detected in | HepG2 cells, HEK-293 cells, Jurkat cells, Raji cells |
| Positive IHC detected in | human breast cancer tissue, mouse liver tissue, human colon cancer tissue, human liver cancer tissue Note: suggested antigen retrieval with TE buffer pH 9.0; (*) Alternatively, antigen retrieval may be performed with citrate buffer pH 6.0 |
| Positive FC (Intra) detected in | HepG2 cells |
推荐稀释比
| 应用 | 推荐稀释比 |
|---|---|
| Western Blot (WB) | WB : 1:1000-1:5000 |
| Immunohistochemistry (IHC) | IHC : 1:50-1:500 |
| Flow Cytometry (FC) (INTRA) | FC (INTRA) : 0.40 ug per 10^6 cells in a 100 µl suspension |
| It is recommended that this reagent should be titrated in each testing system to obtain optimal results. | |
| Sample-dependent, Check data in validation data gallery. | |
产品信息
24168-1-AP targets XBP1S/XBP1U in WB, IHC, FC (Intra), ChIP, ELISA applications and shows reactivity with human, mouse samples.
| 经测试应用 | WB, IHC, FC (Intra), ELISA Application Description |
| 文献引用应用 | WB, IHC, ChIP |
| 经测试反应性 | human, mouse |
| 文献引用反应性 | human, mouse, rat |
| 免疫原 |
CatNo: Ag21454 Product name: Recombinant human XBP1 protein Source: e coli.-derived, PET30a Tag: 6*His Domain: 1-167 aa of BC000938 Sequence: MVVVAAAPNPADGTPKVLLLSGQPASAAGAPAGQALPLMVPAQRGASPEAASGGLPQARKRQRLTHLSPEEKALRRKLKNRVAAQTARDRKKARMSELEQQVVDLEEENQKLLLENQLLREKTHGLVVENQELRQRLGMDALVAEEEAEAKGNEVRPVAGSAESAAL 种属同源性预测 |
| 宿主/亚型 | Rabbit / IgG |
| 抗体类别 | Polyclonal |
| 产品类型 | Antibody |
| 全称 | X-box binding protein 1 |
| 别名 | XBP1, Tax-responsive element-binding protein 5, TREB-5, X box binding protein 1, X-box-binding protein 1 |
| 计算分子量 | 261 aa, 29 kDa |
| 观测分子量 | ~32 kDa; ~60 kDa |
| GenBank蛋白编号 | BC000938 |
| 基因名称 | XBP1 |
| Gene ID (NCBI) | 7494 |
| RRID | AB_2879445 |
| 偶联类型 | Unconjugated |
| 形式 | Liquid |
| 纯化方式 | Antigen Affinity purified |
| UNIPROT ID | P17861 |
| 储存缓冲液 | PBS with 0.02% sodium azide and 50% glycerol, pH 7.3. |
| 储存条件 | Store at -20°C. Stable for one year after shipment. Aliquoting is unnecessary for -20oC storage. |
背景介绍
XBP1 is also named as XBP2, belongs to the bZIP family. The X-box-binding protein-1 (XBP1) is a transcriptional regulator of the ER stress response that lies downstream of inositol-requiring enzyme 1 (IRE1α) activation (PMID: 14559994). IRE1α possesses both kinase and ribonuclease activity and processes XBP1 mRNA to produce an active transcription factor in response to ER stress (PMID: 11779464, 11780124). It has been found that upon accumulation of unfolded proteins in the endoplasmic reticulum, the mRNA of this gene is processed to an active form by an unconventional splicing mechanism that is mediated by the endonuclease inositol-requiring enzyme 1. The resulting loss of 26 nt from the spliced mRNA causes a frame-shift and an isoform XBP1S, which is the functionally active transcription factor. The isoform encoded by the unspliced mRNA, XBP1U, is constitutively expressed, and thought to function as a negative feedback regulator of XBP1S, which shuts off transcription of target genes during the recovery phase of ER stress (PMID: 11850408). The unspliced XBP1U isoform is composed of 261 amino acid residues, and the spliced XBP1S isoform is composed of 376 amino acid residues. The XBP1 antibody (24168-1-AP) can detect both XBP1U and XBP1S.
实验方案
| Product Specific Protocols | |
|---|---|
| FC protocol for XBP1S/XBP1U antibody 24168-1-AP | Download protocol |
| IHC protocol for XBP1S/XBP1U antibody 24168-1-AP | Download protocol |
| WB protocol for XBP1S/XBP1U antibody 24168-1-AP | Download protocol |
| Standard Protocols | |
|---|---|
| Click here to view our Standard Protocols |
发表文章
| Species | Application | Title |
|---|---|---|
J Hazard Mater GRP78/IRE1 and cGAS/STING pathway crosstalk through CHOP facilitates iodoacetic acid-mediated testosterone decline | ||
Aging Cell HSPA12B Protects Against Age-Related Endothelial Cell Senescence by Regulating STING Degradation | ||
J Ethnopharmacol Network pharmacology, molecular docking, and in vitro experimental verification of the mechanism of Guanxining in treating diabetic atherosclerosis | ||
Bioorg Chem Dihydroartemisinin alleviates steatosis and inflammation in nonalcoholic steatohepatitis by decreasing endoplasmic reticulum stress and oxidative stress. | ||
J Virol Inositol requiring enzyme 1α promotes Zika virus infection through regulating stearoyl-CoA desaturase 1 mediated lipid metabolism.
| ||
Exp Ther Med Apelin‑13 reduces high glucose‑induced mitochondrial dysfunction in cochlear hair cells by inhibiting endoplasmic reticulum stress |